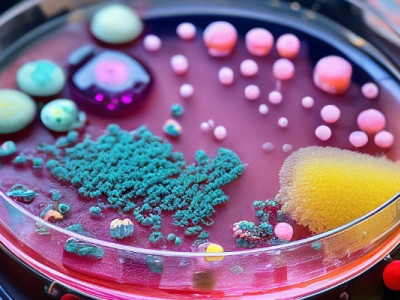
Небезпечний продукт потрапив до України

Небезпечний продукт потрапив до України
- Останні
- Популярні
- Травень, 31
-
-
- Травень, 30
-
-
-
-
-
-
-
-
-
-
-
-
- Травень, 29
-
-
-
-
-
Більше новин
Більше новин
Новини по днях
Сьогодні,
1 червня 2025
1 червня 2025
Новини на тему
Більше новин